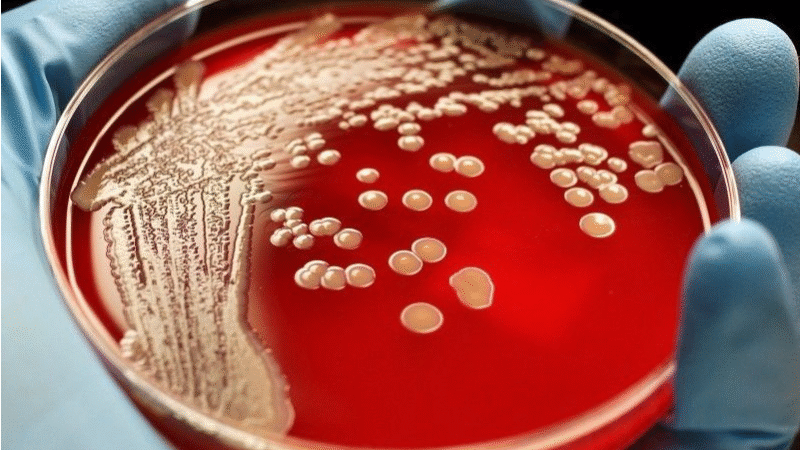

Свиной цепень — вид глистов, которым может заразиться любой любитель мяса.
Свиной цепень пути заражения
Свиной цепень в качестве промежуточных хозяев использует собак, кроликов, свиней. Но окончательным хозяином выступает только человек. Это паразитарное заболевание называется тениоз. Болезнь очень опасна и вызывает множество осложнения, поэтому лечение свиного цепня обязательно. И чем раньше, тем лучше
Паразит достигает размеров до 2-3 м с четырьмя присосками на голове. За счет этого он крепко цепляется внутри кишечника человека
Заразиться ним можно через употребление в пищу плохо приготовленного свиного мяса. Уже больной может заражать остальных людей личинками
Симптомы Тениоза, Свиного цепня
- Тошнота
- Рвота
- Потеря веса
- Отсутствие аппетита
- Боль в животе
- Зуд анального отверстия
- Головные боли
- Нехватка железа

Но стоит учесть, если свиной цепень поражает головной мозг, то у больного может наблюдаться головокружение, нарушение речи, галлюцинации и психические отклонения
Если паразит в глазу, то появляются покраснения глазного яблока, которые часто путают с конъюнктивитом
Диагностика свиного цепня
Определить наличие этого вида глиста можно по анализам. Также в нашей клинике можно получить анализ состояния с применением системы Комплекс Медицинский Экспертный
Методы лечения Свиного цепня
Лечение свиного цепня, как и власоглав, острицы и других глистных заболеваний с помощью противопаразитарной программы в Киеве в Медицинском центре «Альтернатива». Это два последовательных курса по 5 дней с очищающей программой. Так за это время очищается печень, кровь, сосуды, кишечник, лимфа и другие органы от токсинов, глистных инвазий, бактерий и грибков
Также используется лечение с помощью ректальных инсуффляций, микроклизмы с озонированным оливковым маслом и приема озонированной воды. Если необходимо, в качестве домашнего лечения назначается лечебная диета, ректальные свечи или гомеопатия
Преимущества диагностики и лечения свиного цепня в МЦ «Альтернатива»
- Все лечение проводится без токсических лекарств
- Очищается весь организм, что способствует нормальному функционированию всех органов
- Повышается иммунитет
- Программа разработана отдельно для взрослых и детей
- Есть возможность выбора стационарного или амбулаторного лечения

Дуже це тяжка хвороба,але за допомогою Альтернативи,в мене все добре.
Лікувався близько року,звертався в клініку не один раз.
Але комплесне лікування допомає.Це і озон,і спеціальне лікування на КМЕ,і харчування,і очищення кишківника і печінки.Тільки таблетками я б таких результатів не досягнув.